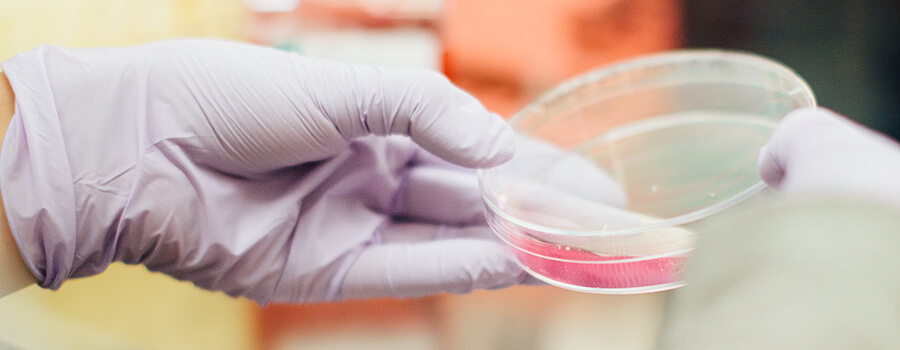
Gloved hand holding a petri dish.

Essential Skills for Landing Your
Dream Job in Life Sciences
See also: Careers in Life Sciences
Life sciences can be a rewarding and lucrative career path. With an average salary just shy of $140,000 per year, a life sciences professional can live comfortably just about anywhere in America. The ability to work in an industry that is constantly innovating and developing new ways to improve human health is undeniably rewarding.
However, getting a job in life sciences isn't always easy. The competition can be fierce, and the industry itself is constantly changing. This article will discuss the five must-have skills for landing a job in life sciences.
What Jobs Are Available in Life Sciences?
The first step in finding the right job in life sciences is understanding what kinds of jobs are available. The life sciences industry includes a wide range of sub-disciplines, each with its own unique career paths. For example, many life scientists work in the pharmaceutical industry, developing new drugs and treatments. Others may work in the agricultural industry, developing new ways to improve crop yields or developing new strains of crops that are resistant to disease.
Others may work in the cosmetics industry, developing new formulations for makeup and skincare products. Many life scientists work in academia, conducting research and teaching at colleges and universities. A few of the most common occupations in the life sciences industry include:
- Biochemists and biophysicists
- Biological technicians
- Medical scientists
- Microbiologists
- Pharmacists
- Physicians and surgeons
- Zoologists and wildlife biologists
What Skills Are Needed for a Job in Life Sciences?
The skills needed for a job in life sciences vary depending on the specific occupation. However, there are a few skills that are essential for just about any job in the life sciences industry.
1. Research and Analytical Skills
Life scientists must have strong analytical skills. They need to be able to understand complex data sets and make sound conclusions based on that data. They also need to be excellent communicators, both in writing and in person. This is because they will often be working with other scientists, as well as non-scientists who may not be familiar with the jargon of the life sciences. Research skills also play a critical role in a life scientist's job. They need to be able to design and carry out experiments, as well as analyze the results of those experiments.
2. A Broad Understanding of Science
The exact type of science you need to know will depend on the specific job you're applying for, but another important skill you need for a career in life sciences is a broad understanding of science. Life sciences is a broad field that covers many different subtopics, from biology to chemistry to physics. Employers will often look for candidates with a degree in one of these fields.
However, having a degree is not enough. To be truly successful in life sciences, you need to have a deep understanding of the subject matter. You should be able to explain complicated scientific concepts clearly and concisely. You should also be comfortable working with complex data sets, such as analyzing DNA sequences or modeling protein interactions.
3. Computational Skills
In today's world, almost all data is stored electronically. This means that life scientists need to be comfortable working with computers. They need to be able to use basic statistical software (such as Excel) to analyze data sets. They also might need to be familiar with more sophisticated programs (such as R or SAS) that are often used in research. With life science companies using AI to develop sales and product strategies, many employers are also seeking out candidates with skills in AI, process automation, and machine learning.
4. Ecommerce
Many life science companies now look for candidates with ecommerce skills. This is because many life science products are sold online through the company's website. These companies need employees who are familiar with ecommerce platforms (such as Shopify or Magento) and can help design and implement an effective online sales strategy.
Ecommerce skills are also important for life scientists who want to sell their products directly to consumers through an online store. For example, many biochemists and microbiologists now sell their products (such as cosmetics or skincare products) through their own websites and their own brands. In some cases, they even manufacture their products in-house.
5. Marketing
While marketing is not traditionally thought of as a "skill" for life scientists, it is becoming increasingly important for those working in the industry. This is because many life science companies are now selling their products directly to consumers. These companies need employees who are familiar with marketing concepts and can help create and implement an effective marketing strategy.
Other Prerequisites for Jobs in Life Sciences
In addition to the skills mentioned above, there are a few other skills that are often required for jobs in the life sciences industry. These include:
Project management: Life scientists often work on multiple projects at the same time. As such, they need to be able to effectively manage their time and resources.
Data analysis: Life scientists often work with large data sets, and they need to be able to quickly and accurately analyze this data to find trends and patterns.
Communication: The ability to communicate findings clearly and concisely, both in writing and in person goes a long way in life science. They also need to be able to listen to and understand the critiques of their peers.
A life sciences executive search firm will also require either a four-year degree or a Ph.D. in a life science discipline. In some cases, employers may also require experience working in a laboratory or another scientific setting. If this is the case, there are a few things you can do to make yourself a more attractive candidate:
- Get involved in research studies as an undergrad and graduate student
- Publish your findings in scientific journals
- Attend conferences and networking events
- Build a network and a personal and personal brand
Endnote
Life sciences can be a difficult field to get into; its high cost of school attendance, the long hours, and the need for advanced skills can make it seem unattainable. However, with the right skills and a little bit of effort, anyone can get their foot in the door of this ever-growing, highly innovative industry.
About the Author
Ronica Samuel: I began writing as a professional on my personal blog and then discovered my true calling, which is writing about technology, news and gadgets in general. I have been a technical writer, author, and blogger since 2010. I am an industry watcher who stays on top of the latest features and am extremely passionate about juicy tech news and anything related to gadgets.

